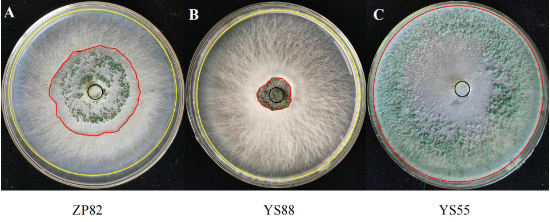

近日,国家食用菌产业技术体系病害防控岗位科学家、华中农业大学农业微生物资源发掘与利用全国重点实验室肖扬教授团队在微生物学国际期刊Environmental Microbiology发表了题为“Genome-wide association study identified an α/β hydrolase gene LeABH enhancing Lentinula edodes resistance to Trichoderma”的研究论文。

木霉属(Trichoderma spp.)真菌严重危害香菇(Lentinula edodes)产业,导致产量和品质的大幅下降。团队研发了一种基于图像的量化评估方法,通过木霉感染率(TIR)来评估香菇的抗性水平。通过对不同香菇菌株TIR的量化分析,团队进行了全基因组关联分析,鉴定出239个显著关联的单核苷酸多态性(SNPs)位点及245个候选基因。其中部分基因涉及细胞膜完整性维持、物质运输及环境应激反应,可能与木霉抗性相关。
值得注意的是,位于第3、9和10号染色体上的3个SNPs与多个TIR性状稳定相关,涉及6个候选基因。进一步,团队验证了其中一个 α / β 水解酶基因LeABH的功能。在香菇中过表达LeABH可显著增强其对哈茨木霉(T. harzianum)的抗性,提高幅度达26.7%-33.4%,也可显著增强其对深绿木霉(T. atroviride)的抗性,提高幅度达21.4%-49.7%,还可抑制木霉分生孢子形成。这些结果表明LeABH是调控香菇木霉抗性的重要功能基因。该研究有助于阐明香菇木霉抗性的遗传基础。改进的抗性评估方法,及已鉴定的遗传变异和候选基因,将为香菇抗性品种的分子标记辅助育种提供有益资源。
本研究获得了国家重点研发计划和国家食用菌产业技术体系的资助。
文章链接:https://doi.org/10.1111/1462-2920.70251
图1.基于图像的香菇木霉抗性评价(A-C分别代表抗性、高抗和高感香菇菌株)

图2. 全基因组关联分析中的曼哈顿图(左)与QQ图(右)

图3. 过表达LeABH基因对香菇哈茨木霉和深绿木霉抗性的作用
